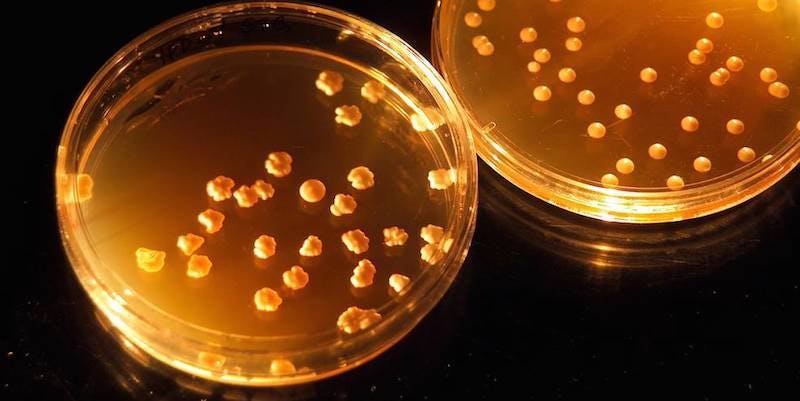

NASA awarded a large sum of money to researchers looking to turn astronaut poop into food.
According to a press release on NASA's website, eight faculty-led teams received about $200,000 per year for up to three years of research dealing with high priority needs for the future of space exploration. Among the proposed projects is Clemson University's "Synthetic Biology for Recycling Human Waste into Food, Nutraceuticals, and Materials: Closing the Loop for Long-Term Space Travel."
NASA currently pays commercial space travel firms like SpaceX to bring supplies to astronauts at the International Space Station (ISS). But for trips farther into the solar system, astronauts will need huge amounts of food to sustain themselves for months or even years.
Astronauts will, therefore, have to produce their own food, and it appears human waste might be the key to eliminating shortages and possibly making a home out of Mars.
In the press release, Steve Jurczyk, an associate administrator for NASA's Space Technology Mission Directorate at the agency's headquarters in Washington, said,
These early career researchers will provide fuel for NASA's innovation engine. Technology drives exploration, and investments in these technologies and technologists is essential to ensure NASA and the nation have the capabilities necessary to meet the challenges we will face as we journey to Mars. The faculty selected and their colleagues help assure a robust university research community dedicated to advanced space technology development.
ISS astronauts made a major leap toward self-sustainability last May by successfully growing lettuce in space. If human waste can be made to taste nearly as good as that red romaine lettuce, Mars could merely be the starting point for a series of journeys into the deepest depths of space.
Citations: NASA Awards Grants for Technologies That Could Transform Space Exploration (NASA)